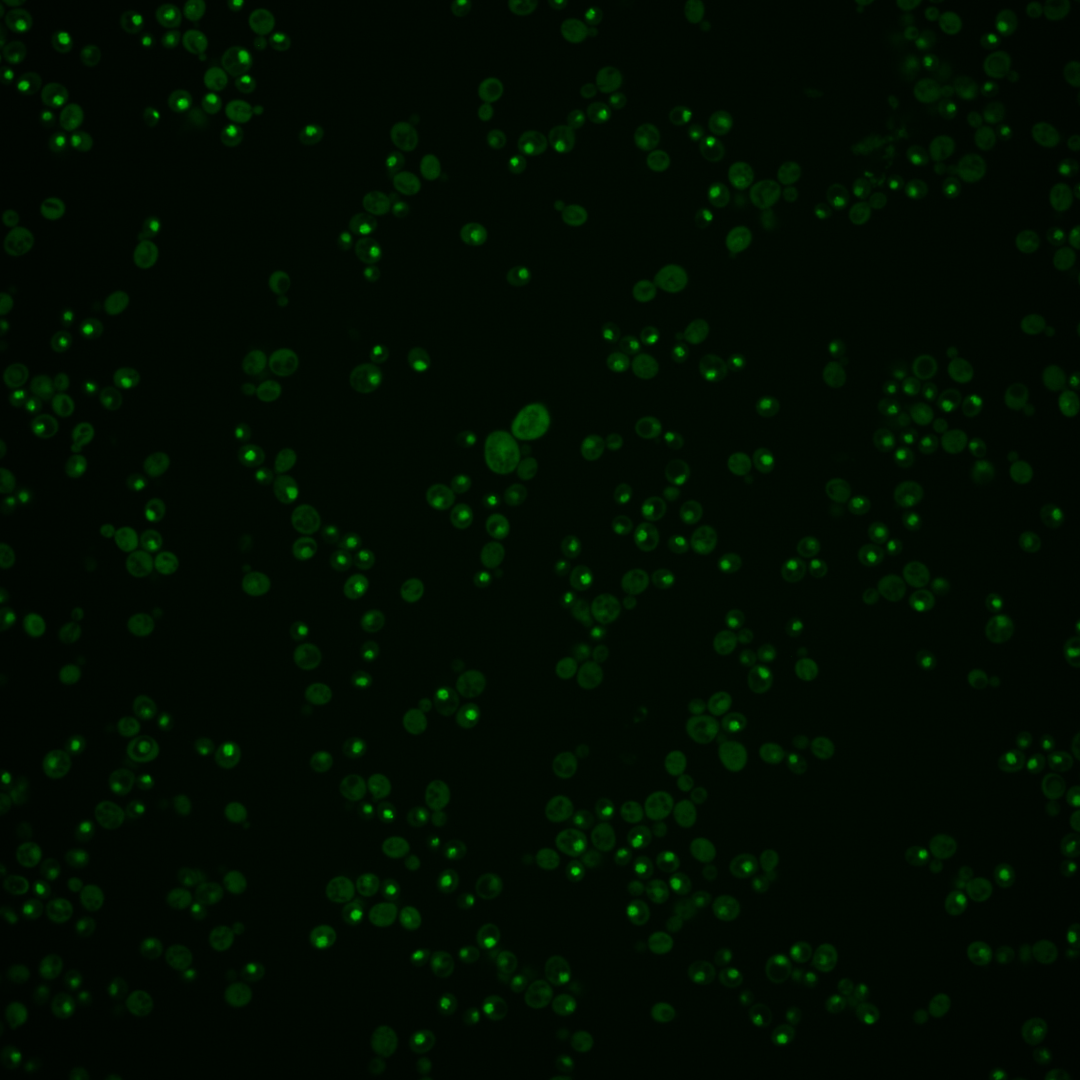
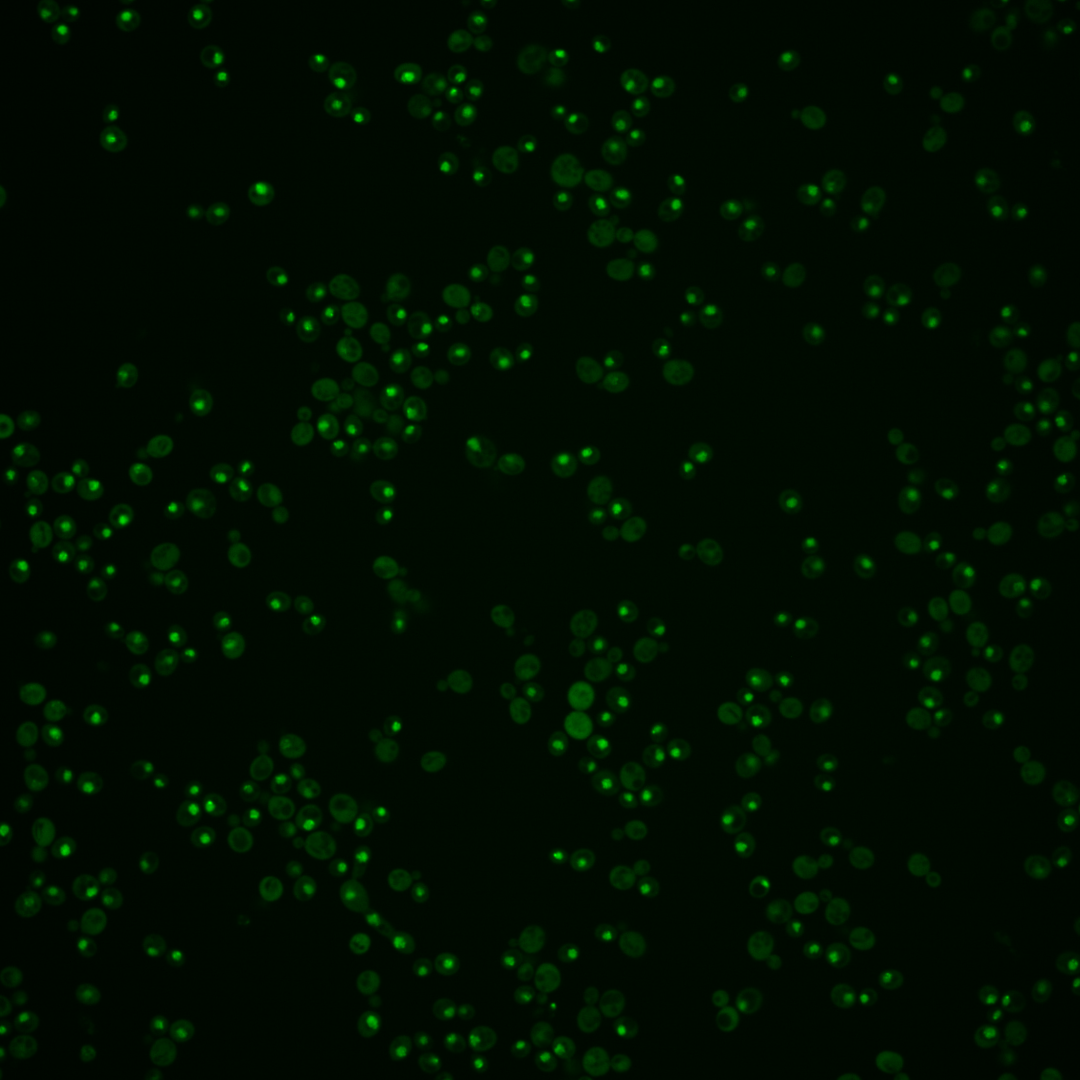

| Standard name | |
|---|---|
| Human Ortholog | |
| Description | Component of the Mcm2-7 hexameric helicase complex; MCM2-7 primes origins of DNA replication in G1 and becomes an active ATP-dependent helicase that promotes DNA melting and elongation in S-phase; forms an Mcm4p-6p-7p subcomplex |
Micrographs




















































































Sub-cellular Localization
Yeast GFP Assignment
Protein Abundance
Localization Change
External localization resources
| ensLOC | DeepLoc | |||||||||||||||||||||||
|---|---|---|---|---|---|---|---|---|---|---|---|---|---|---|---|---|---|---|---|---|---|---|---|---|
| Localization | WT1 | WT2 | WT3 | RAP60 | RAP140 | RAP220 | RAP300 | RAP380 | RAP460 | RAP540 | RAP620 | RAP700 | HU80 | HU120 | HU160 | rpd3Δ_1 | rpd3Δ_2 | rpd3Δ_3 | WT1 | WT2 | WT3 | AF100 | AF140 | AF180 |
| Cortical Patches | 0 | 0 | 1 | 0 | 2 | 0 | 1 | 1 | 0 | – | 1 | 0 | 0 | 0 | 1 | 0 | 0 | 0 | 0 | 0 | 0 | 0 | 0 | 0 |
| Bud | 4 | 1 | 4 | 3 | 6 | 5 | 9 | 10 | 14 | – | 9 | 9 | 0 | 0 | 0 | 0 | 0 | 0 | 15 | 22 | 30 | 20 | 7 | 9 |
| Bud Neck | 0 | 0 | 0 | 0 | 2 | 3 | 2 | 8 | 2 | – | 2 | 3 | 1 | 0 | 0 | 0 | 0 | 0 | 2 | 2 | 2 | 1 | 4 | 3 |
| Bud Site | 0 | 0 | 0 | 0 | 1 | 3 | 1 | 0 | 6 | – | 5 | 5 | 0 | 0 | 0 | 0 | 0 | 0 | – | – | – | – | – | – |
| Cell Periphery | 0 | 1 | 1 | 1 | 0 | 2 | 4 | 8 | 2 | – | 2 | 3 | 0 | 1 | 1 | 6 | 4 | 6 | 0 | 0 | 0 | 0 | 0 | 0 |
| Cytoplasm | 61 | 58 | 97 | 69 | 172 | 117 | 125 | 123 | 80 | – | 54 | 69 | 33 | 90 | 115 | 181 | 99 | 97 | 39 | 31 | 53 | 18 | 3 | 1 |
| Endoplasmic Reticulum | 0 | 1 | 0 | 0 | 0 | 0 | 1 | 0 | 0 | – | 0 | 1 | 0 | 1 | 1 | 12 | 6 | 5 | 0 | 0 | 0 | 1 | 0 | 1 |
| Endosome | 7 | 5 | 3 | 6 | 12 | 12 | 8 | 10 | 4 | – | 0 | 1 | 6 | 18 | 28 | 4 | 7 | 5 | 8 | 3 | 6 | 2 | 15 | 37 |
| Golgi | 0 | 0 | 0 | 2 | 0 | 0 | 0 | 1 | 0 | – | 0 | 0 | 0 | 0 | 0 | 2 | 1 | 1 | 1 | 1 | 0 | 0 | 4 | 3 |
| Mitochondria | 7 | 2 | 1 | 1 | 4 | 31 | 26 | 21 | 84 | – | 73 | 42 | 3 | 1 | 3 | 3 | 0 | 1 | 1 | 0 | 2 | 0 | 4 | 10 |
| Nucleus | 82 | 139 | 117 | 143 | 151 | 157 | 226 | 239 | 191 | – | 150 | 200 | 288 | 281 | 240 | 169 | 102 | 92 | 104 | 143 | 121 | 167 | 205 | 204 |
| Nuclear Periphery | 1 | 1 | 0 | 1 | 5 | 14 | 17 | 24 | 21 | – | 4 | 5 | 0 | 5 | 12 | 3 | 0 | 1 | 0 | 0 | 0 | 0 | 2 | 13 |
| Nucleolus | 22 | 21 | 5 | 18 | 38 | 59 | 68 | 72 | 86 | – | 66 | 74 | 39 | 111 | 118 | 14 | 11 | 5 | 29 | 21 | 13 | 43 | 172 | 210 |
| Peroxisomes | 0 | 0 | 0 | 0 | 0 | 0 | 0 | 0 | 0 | – | 0 | 0 | 0 | 0 | 0 | 0 | 0 | 0 | 0 | 0 | 0 | 0 | 0 | 0 |
| SpindlePole | 0 | 0 | 0 | 2 | 3 | 3 | 4 | 11 | 2 | – | 0 | 0 | 0 | 1 | 0 | 2 | 2 | 1 | 4 | 9 | 8 | 7 | 10 | 23 |
| Vac/Vac Membrane | 17 | 14 | 28 | 12 | 35 | 17 | 17 | 31 | 10 | – | 9 | 13 | 26 | 47 | 76 | 51 | 32 | 38 | 8 | 7 | 8 | 16 | 88 | 119 |
| Unique Cell Count | 184 | 232 | 242 | 245 | 397 | 371 | 452 | 490 | 393 | 297 | 363 | 373 | 523 | 551 | 412 | 241 | 228 | 220 | 245 | 252 | 281 | 526 | 649 | |
| Labelled Cell Count | 201 | 243 | 257 | 258 | 431 | 423 | 509 | 559 | 502 | 375 | 425 | 396 | 556 | 595 | 447 | 264 | 252 | 220 | 245 | 252 | 281 | 526 | 649 | |
Yeast GFP Assignment
Protein Abundance
| Screen | WT1 | WT2 | WT3 | RAP60 | RAP140 | RAP220 | RAP300 | RAP380 | RAP460 | RAP540 | RAP620 | RAP700 | HU80 | HU120 | HU160 | rpd3Δ_1 | rpd3Δ_2 | rpd3Δ_3 | AF100 | AF140 | AF180 |
|---|---|---|---|---|---|---|---|---|---|---|---|---|---|---|---|---|---|---|---|---|---|
| Mean Cell GFP Intensity (1e-4) | 11.8 | 12.3 | 10.1 | 9.9 | 9.2 | 7.6 | 7.5 | 8.2 | 6.7 | – | 6.3 | 6.5 | 13.2 | 13.4 | 13.0 | 15.5 | 16.0 | 15.0 | 11.2 | 11.3 | 11.7 |
| Std Deviation (1e-4) | 3.5 | 3.2 | 2.0 | 2.2 | 1.9 | 1.9 | 1.9 | 2.0 | 1.9 | – | 1.8 | 1.6 | 3.1 | 2.9 | 2.8 | 4.6 | 4.9 | 4.7 | 2.7 | 2.3 | 2.1 |
| Intensity Change (Log2) | – | – | – | -0.03 | -0.13 | -0.41 | -0.43 | -0.3 | -0.59 | – | -0.69 | -0.63 | 0.39 | 0.41 | 0.37 | 0.62 | 0.66 | 0.57 | 0.15 | 0.16 | 0.21 |
Localization Change
| Localization | RAP60 | RAP140 | RAP220 | RAP300 | RAP380 | RAP460 | RAP540 | RAP620 | RAP700 | HU80 | HU120 | HU160 | rpd3Δ_1 | rpd3Δ_2 | rpd3Δ_3 |
|---|---|---|---|---|---|---|---|---|---|---|---|---|---|---|---|
| Cortical Patches | 0 | 0 | 0 | 0 | 0 | 0 | – | 0 | 0 | 0 | 0 | 0 | 0 | 0 | 0 |
| Bud | 0 | 0 | 0 | 0 | 0 | 1.4 | – | 1.0 | 0.7 | 0 | 0 | 0 | 0 | 0 | 0 |
| Bud Neck | 0 | 0 | 0 | 0 | 0 | 0 | – | 0 | 0 | 0 | 0 | 0 | 0 | 0 | 0 |
| Bud Site | 0 | 0 | 0 | 0 | 0 | 0 | – | 0 | 0 | 0 | 0 | 0 | 0 | 0 | 0 |
| Cell Periphery | 0 | 0 | 0 | 0 | 0 | 0 | – | 0 | 0 | 0 | 0 | 0 | 0 | 0 | 0 |
| Cytoplasm | -2.8 | 0.8 | -2.2 | -3.3 | -4.2 | -5.4 | – | -5.6 | -5.7 | -9.3 | -6.8 | -5.6 | 1.0 | 0.2 | 0.5 |
| Endoplasmic Reticulum | 0 | 0 | 0 | 0 | 0 | 0 | – | 0 | 0 | 0 | 0 | 0 | 0 | 0 | 0 |
| Endosome | 0 | 1.4 | 1.6 | 0 | 0 | 0 | – | 0 | 0 | 0 | 1.7 | 2.6 | 0 | 0 | 0 |
| Golgi | 0 | 0 | 0 | 0 | 0 | 0 | – | 0 | 0 | 0 | 0 | 0 | 0 | 0 | 0 |
| Mitochondria | 0 | 0 | 4.3 | 3.5 | 2.9 | 7.5 | – | 8.1 | 5.2 | 0 | 0 | 0 | 0 | 0 | 0 |
| Nucleus | 2.2 | -2.6 | -1.5 | 0.4 | 0.1 | 0.1 | – | 0.5 | 1.6 | 7.4 | 1.4 | -1.2 | -1.8 | -1.3 | -1.7 |
| Nuclear Periphery | 0 | 0 | 3.1 | 3.1 | 3.5 | 3.7 | – | 0 | 0 | 0 | 0 | 0 | 0 | 0 | 0 |
| Nucleolus | 2.7 | 3.7 | 5.5 | 5.3 | 5.2 | 6.9 | – | 6.9 | 6.6 | 3.9 | 6.9 | 6.9 | 1.0 | 1.5 | 0 |
| Peroxisomes | 0 | 0 | 0 | 0 | 0 | 0 | – | 0 | 0 | 0 | 0 | 0 | 0 | 0 | 0 |
| SpindlePole | 0 | 0 | 0 | 0 | 0 | 0 | – | 0 | 0 | 0 | 0 | 0 | 0 | 0 | 0 |
| Vacuole | -2.7 | -1.1 | -3.2 | -4.0 | -2.5 | -4.7 | – | -3.9 | -3.8 | -2.0 | -1.1 | 0.9 | 0.3 | 0.6 | 1.6 |
External localization resources
Images






























Protein Concentration and Protein Localization Data
| R1 | R2 | R3 | ||||||||||||||||
|---|---|---|---|---|---|---|---|---|---|---|---|---|---|---|---|---|---|---|
| G1 Pre-START | G1 Post-START | S/G2 | Metaphase | Anaphase | Telophase | G1 Pre-START | G1 Post-START | S/G2 | Metaphase | Anaphase | Telophase | G1 Pre-START | G1 Post-START | S/G2 | Metaphase | Anaphase | Telophase | |
| Concentration | 9.9669 | 9.373 | 8.5317 | 7.3051 | 6.9124 | 9.5968 | 7.0106 | 8.1753 | 6.1015 | 4.4311 | 5.0125 | 7.8467 | 8.1131 | 9.637 | 7.2308 | 5.5732 | 5.225 | 8.792 |
| Actin | 0.0022 | 0.001 | 0.0125 | 0.0031 | 0.0062 | 0.0026 | 0.0305 | 0.0118 | 0.0097 | 0.0081 | 0.0192 | 0.0004 | 0.0118 | 0.003 | 0.0076 | 0.0465 | 0.006 | 0.0144 |
| Bud | 0.0012 | 0.0206 | 0.0466 | 0.0673 | 0.0422 | 0.0121 | 0.001 | 0.0322 | 0.0596 | 0.0496 | 0.0411 | 0.0006 | 0.0004 | 0.0112 | 0.034 | 0.0427 | 0.0451 | 0.0014 |
| Bud Neck | 0.0013 | 0.0043 | 0.0063 | 0.0071 | 0.0155 | 0.0114 | 0.0005 | 0.0016 | 0.0034 | 0.0055 | 0.008 | 0.0061 | 0.0008 | 0.0016 | 0.0048 | 0.0067 | 0.0024 | 0.0045 |
| Bud Periphery | 0.0025 | 0.0131 | 0.0405 | 0.0646 | 0.0443 | 0.0123 | 0.001 | 0.0142 | 0.0327 | 0.0333 | 0.0174 | 0.0009 | 0.0005 | 0.0047 | 0.0201 | 0.044 | 0.0408 | 0.0014 |
| Bud Site | 0.0043 | 0.0626 | 0.0296 | 0.0392 | 0.0197 | 0.0052 | 0.002 | 0.0383 | 0.0204 | 0.0114 | 0.0353 | 0.0008 | 0.0068 | 0.0139 | 0.0129 | 0.0093 | 0.003 | 0.0004 |
| Cell Periphery | 0.0009 | 0.0022 | 0.0027 | 0.0038 | 0.0024 | 0.0007 | 0.0002 | 0.0014 | 0.0014 | 0.0024 | 0.0018 | 0.0007 | 0.0002 | 0.0005 | 0.0013 | 0.0015 | 0.0005 | 0.0002 |
| Cytoplasm | 0.0122 | 0.0708 | 0.3499 | 0.6163 | 0.6386 | 0.053 | 0.0192 | 0.1562 | 0.4001 | 0.6208 | 0.525 | 0.0764 | 0.0097 | 0.0797 | 0.3823 | 0.45 | 0.2583 | 0.0581 |
| Cytoplasmic Foci | 0.0021 | 0.0177 | 0.0085 | 0.0091 | 0.0089 | 0.0028 | 0.009 | 0.0025 | 0.0192 | 0.0236 | 0.0127 | 0.0013 | 0.0253 | 0.002 | 0.0208 | 0.0446 | 0.0298 | 0.001 |
| Eisosomes | 0 | 0 | 0.0001 | 0 | 0 | 0 | 0.0002 | 0 | 0 | 0 | 0.0002 | 0 | 0.0004 | 0 | 0.0003 | 0.0002 | 0.0002 | 0 |
| Endoplasmic Reticulum | 0.0018 | 0.0015 | 0.0126 | 0.0121 | 0.0067 | 0.0009 | 0.0048 | 0.0012 | 0.0046 | 0.0044 | 0.002 | 0.0005 | 0.0026 | 0.0014 | 0.0055 | 0.0074 | 0.0021 | 0.0016 |
| Endosome | 0.0035 | 0.0066 | 0.0079 | 0.0154 | 0.0067 | 0.0026 | 0.0266 | 0.0018 | 0.022 | 0.0424 | 0.0388 | 0.0014 | 0.0133 | 0.0011 | 0.0113 | 0.022 | 0.0152 | 0.0058 |
| Golgi | 0.001 | 0.0006 | 0.0011 | 0.0012 | 0.0007 | 0.0009 | 0.008 | 0.0007 | 0.004 | 0.0495 | 0.0197 | 0.0003 | 0.007 | 0.0002 | 0.002 | 0.0066 | 0.0105 | 0.0009 |
| Lipid Particles | 0.0034 | 0.0007 | 0.0018 | 0.0006 | 0.0005 | 0.0038 | 0.0067 | 0.0002 | 0.0019 | 0.003 | 0.0063 | 0.0003 | 0.0213 | 0.0001 | 0.0087 | 0.0111 | 0.1064 | 0.0013 |
| Mitochondria | 0.0014 | 0.0006 | 0.0041 | 0.0025 | 0.0015 | 0.0013 | 0.0066 | 0.0011 | 0.0063 | 0.0068 | 0.0161 | 0.0091 | 0.0131 | 0.0011 | 0.008 | 0.0059 | 0.1518 | 0.0167 |
| None | 0.001 | 0.001 | 0.0034 | 0.0026 | 0.0283 | 0.0015 | 0.0043 | 0.0006 | 0.0024 | 0.0039 | 0.0012 | 0.0003 | 0.0028 | 0.004 | 0.0087 | 0.0159 | 0.0133 | 0.0004 |
| Nuclear Periphery | 0.0193 | 0.0142 | 0.0337 | 0.008 | 0.0119 | 0.0059 | 0.0209 | 0.0201 | 0.0235 | 0.0122 | 0.0024 | 0.007 | 0.0082 | 0.0103 | 0.0206 | 0.0164 | 0.0066 | 0.007 |
| Nucleolus | 0.031 | 0.0342 | 0.0284 | 0.011 | 0.0034 | 0.1439 | 0.0201 | 0.0168 | 0.026 | 0.0108 | 0.0868 | 0.1412 | 0.0287 | 0.0109 | 0.0163 | 0.0035 | 0.0092 | 0.0822 |
| Nucleus | 0.8944 | 0.7085 | 0.3553 | 0.0777 | 0.1361 | 0.7206 | 0.8073 | 0.6861 | 0.3229 | 0.0703 | 0.1391 | 0.7416 | 0.8088 | 0.8253 | 0.3946 | 0.2285 | 0.231 | 0.7984 |
| Peroxisomes | 0.0078 | 0.0003 | 0.0059 | 0.0004 | 0.0004 | 0.0008 | 0.0054 | 0.0003 | 0.0007 | 0.0016 | 0.0021 | 0.0001 | 0.0047 | 0.0002 | 0.0035 | 0.0071 | 0.0383 | 0.0003 |
| Punctate Nuclear | 0.0014 | 0.0258 | 0.0199 | 0.0084 | 0.0038 | 0.0121 | 0.0191 | 0.0063 | 0.0228 | 0.0057 | 0.0014 | 0.0054 | 0.0312 | 0.0227 | 0.0207 | 0.0096 | 0.0092 | 0.0016 |
| Vacuole | 0.0055 | 0.0127 | 0.0273 | 0.0447 | 0.0198 | 0.0048 | 0.004 | 0.0057 | 0.0134 | 0.0298 | 0.0199 | 0.0052 | 0.0014 | 0.0055 | 0.0129 | 0.0174 | 0.0136 | 0.0015 |
| Vacuole Periphery | 0.0016 | 0.0009 | 0.0022 | 0.0049 | 0.0023 | 0.0007 | 0.0025 | 0.0009 | 0.0031 | 0.0047 | 0.0035 | 0.0006 | 0.001 | 0.0007 | 0.0031 | 0.0034 | 0.0068 | 0.0009 |
Sequencing Data
| R1 | R2 | |||||||||
|---|---|---|---|---|---|---|---|---|---|---|
| G1 Post-START | S/G2 | Metaphase | Anaphase | Telophase | G1 Post-START | S/G2 | Metaphase | Anaphase | Telophase | |
| Gene Expression | 15.6511 | 12.0479 | 63.7342 | 69.9933 | 20.856 | 20.4221 | 27.2122 | 55.1656 | 58.0073 | 35.4332 |
| Translational Efficiency | 0.5524 | 0.7554 | 0.8925 | 0.8534 | 0.8932 | 0.7713 | 0.8169 | 0.7416 | 0.7951 | 0.7289 |
Hit Data
| Dataset | Hit |
|---|---|
| Protein Concentration | ✔ |
| Protein Localization | ✔ |
| Gene Expression | ✔ |
| Translational Efficiency | ✘ |
Endocytosis
| Temp | Actin Patch (Sac6-tdTomato) | Cortical Patch (Sla1-GFP) | Late Endosome (Snf7-GFP) | Vacuole (Vph1-GFP) |
|---|---|---|---|---|
| 37℃ | ||||
| RT |
Cell Cycle Omics
CYCLoPs (Mcm7-GFP)
| Gene / Allele | Actin Patch (Sac6-tdTomato) | Cortical Patch (Sla1-GFP) | Late Endosome (Snf7-GFP) | Vacuole (Sac6-tdTomato) |
|---|
| Gene | Images |
|---|
| Gene | Images |
|---|
Images are not yet available
Images are not yet available